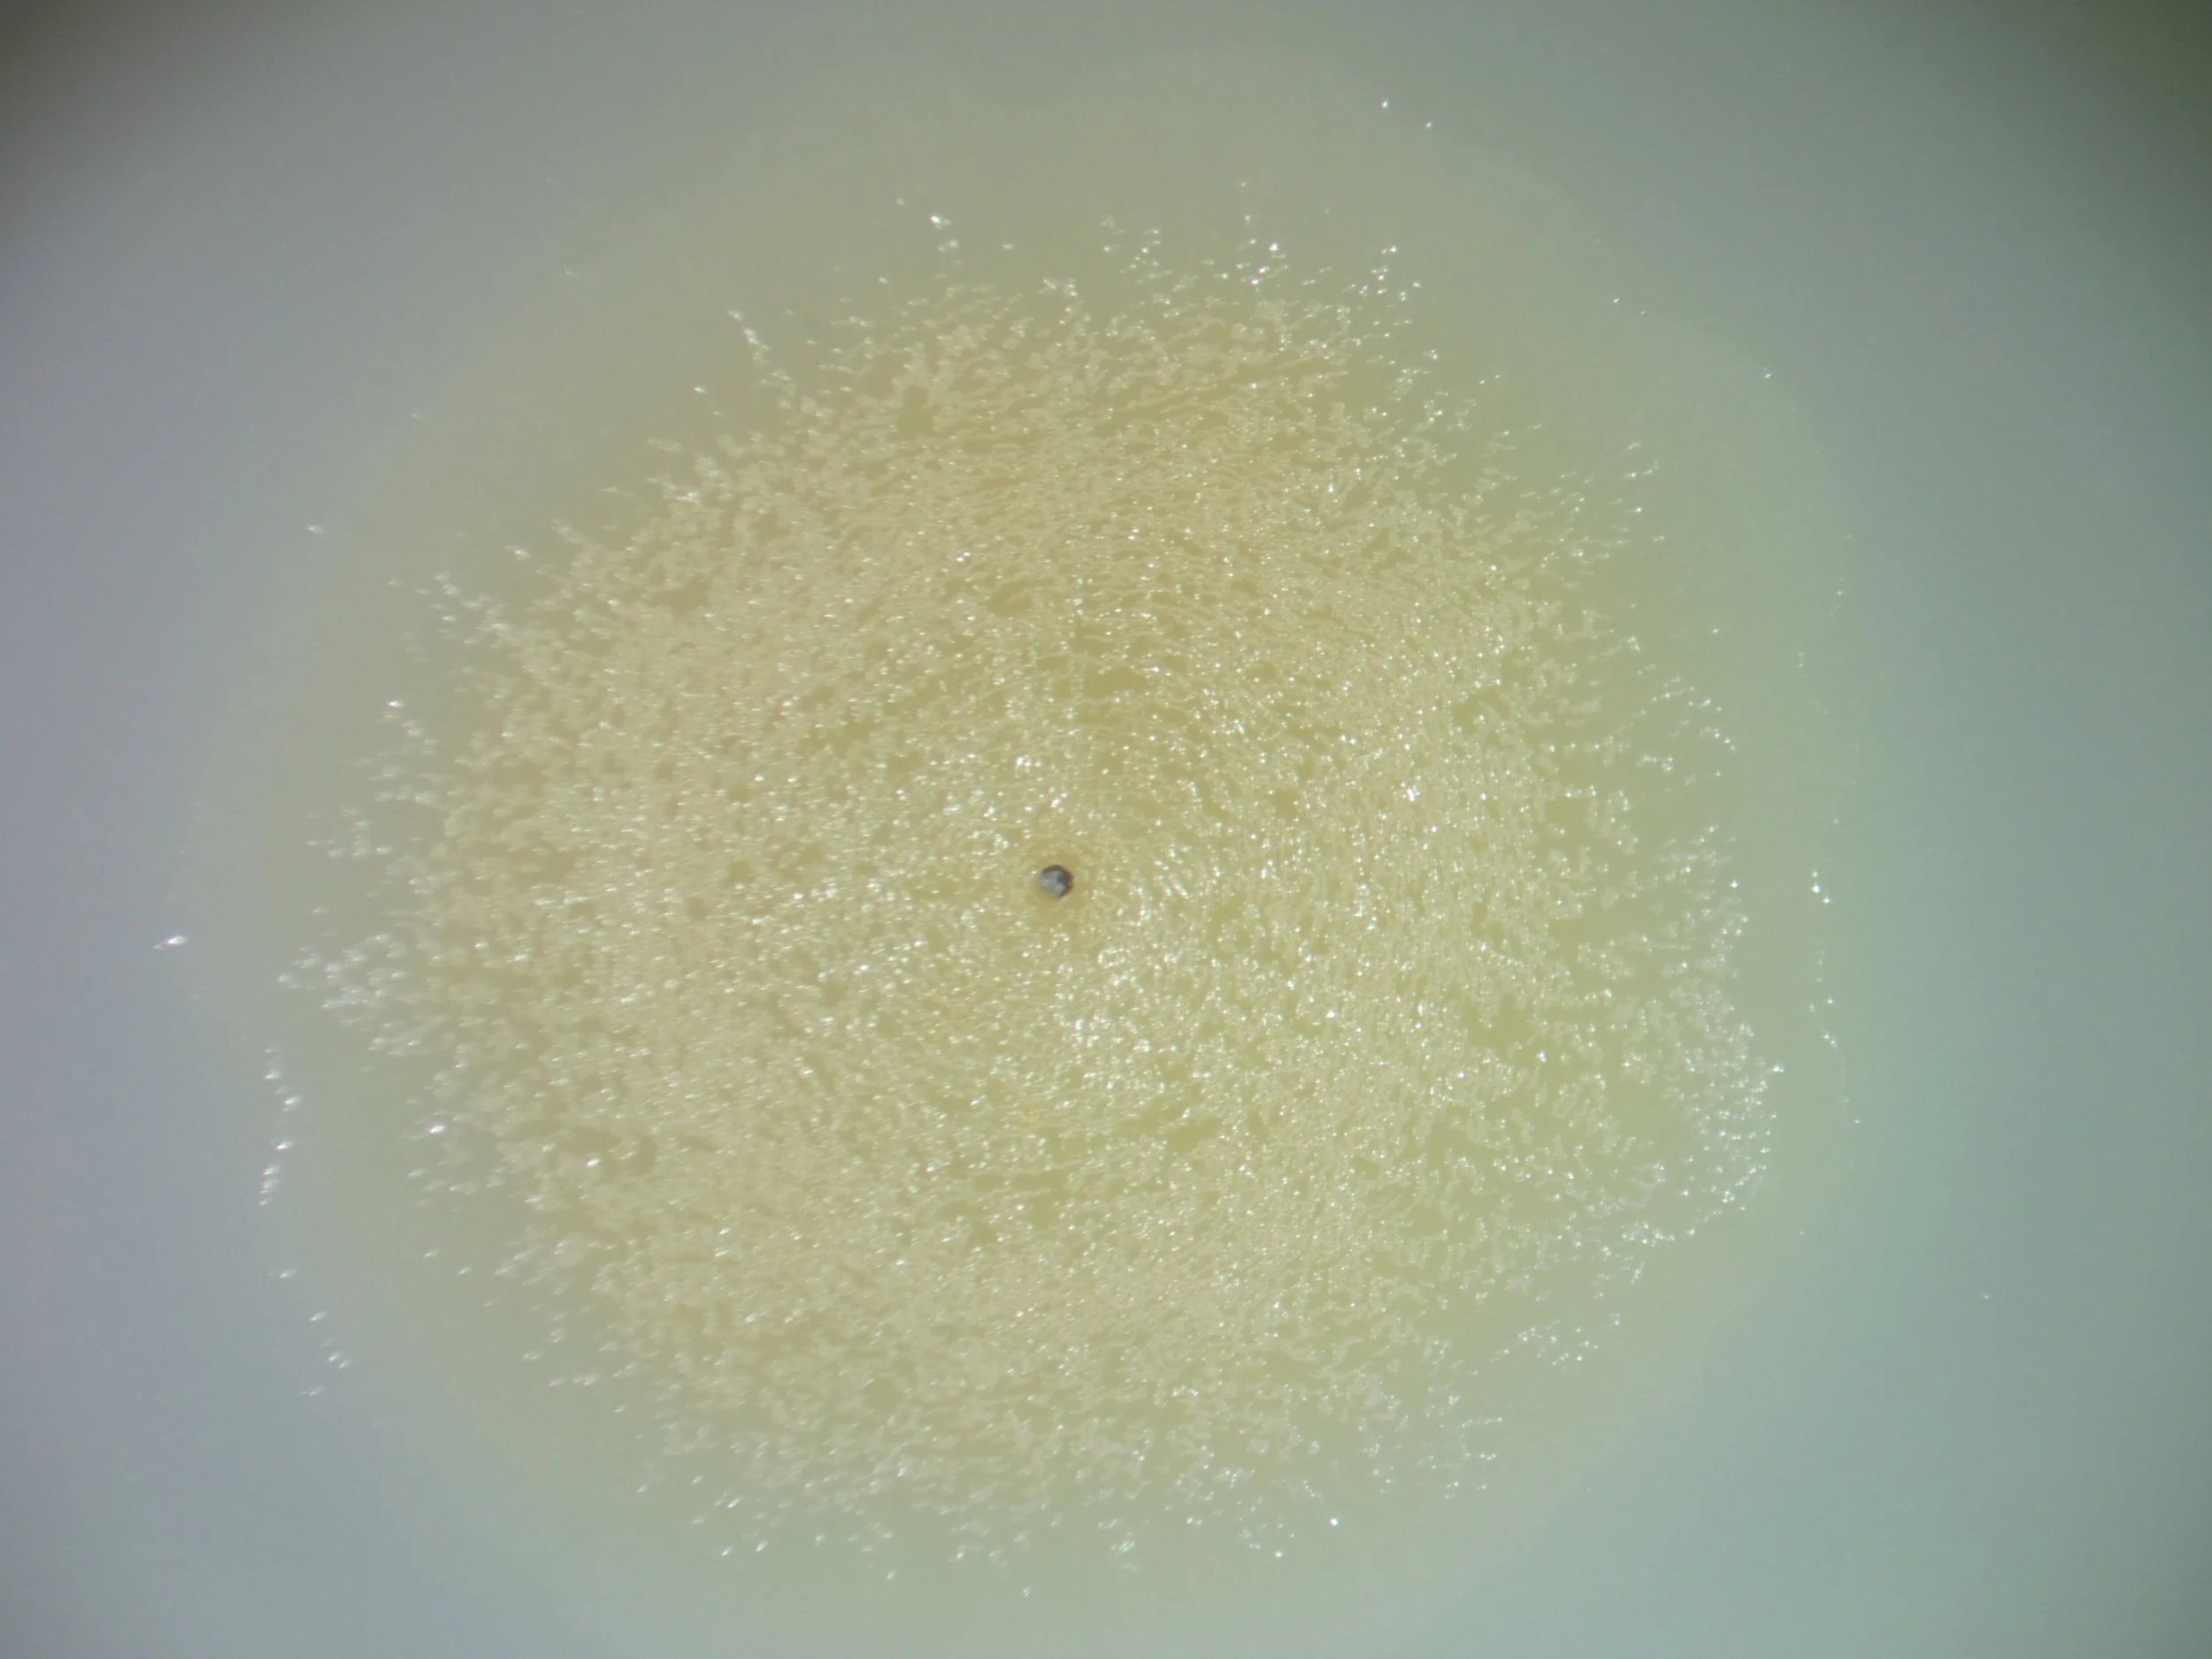

Group Members
kayleigh phillips
4th year phd student
projects:
developing synthetic biology tools for use in myxobacteria (R01GM149795)
nawal shehateh
3rd year phd student
(co-mentor with professor pavl boudreau)
projects:
heterologous expression of myxobacterial BGCs (R01GM149795)
investigating symbiosis in myxobacterial swarm consortia
benjamin tabor
honors college undergraduate
projects:
developing plasmids for use in myxobacteria
natalie elizalde
honors college undergraduate
projects:
investigating symbiosis in myxobacterial swarm consortia
group alumni:
barbara adaikpoh, phd 2021, current - assistant professor, Retzky College of Pharmacy, University of Illinois at Chicago
shukria akbar, phd 2021, current - postdoc at University of Wisconsin-Madison
hanan albataineh, phd 2022, current - assistant professor, College of Pharmacy, Amman Arab University
andrew ahearne, phd 2024, current - postdoc at University of Mississippi with Professor Erik Hom
shailaja khanal pokharel, phd 2025
undergraduates:
thomas knehans, current - chemistry PhD program at Georgia Tech
rachael pace, current - University of Mississippi School of Medicine
katherine gregory, BS in computer science, Sally McDonnell Barksdale Honors College (http://thesis.honors.olemiss.edu/id/eprint/1463)
laura a. salvador
justin caldwell
pillar quinn, current - bioinformatics MSc program at Uppsala University
pharmD students:
alex gochenauer (UM School of Pharmacy Student Research Fellowship Awardee)
logan magana (UM 2019 Distinguished Citation for Outstanding Contributions to Pharmacognosy)
sean harrison (UM 2019 Distinguished Citation for Outstanding Contributions to Pharmacognosy)
william stepp (UM 2019 Distinguished Citation for Outstanding Contributions to Pharmacognosy)
maya duke (UM 2021 Distinguished Citation for Outstanding Contributions to Biomolecular Sciences)
visiting scientists:
sarah moorshead, Clemson University
gage albert
jeffery henry, CBBI fellow, University of Notre Dame, from Rich Taylor’s group
susumu watari, Musashino University, from Koji Ichinose’s group
ARISE students (high school students):
sarah swiderski, mississippi school of math and sciences
cathrine boltz, mississippi school of math and sciences
volunteer high school students:
alex nagle, oxford high school